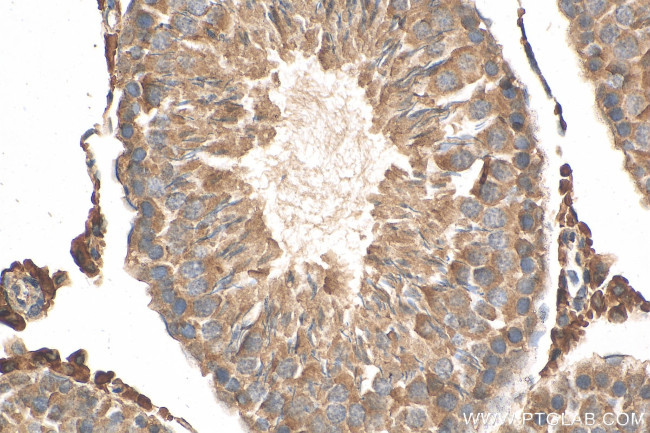
HSD3B2 Antibody in Immunohistochemistry (Paraffin) (IHC (P))

Search
Proteintech
HSD3B2 Polyclonal Antibody
{{$productOrderCtrl.translations['antibody.pdp.commerceCard.promotion.promotions']}}
{{$productOrderCtrl.translations['antibody.pdp.commerceCard.promotion.viewpromo']}}
{{$productOrderCtrl.translations['antibody.pdp.commerceCard.promotion.promocode']}}: {{promo.promoCode}} {{promo.promoTitle}} {{promo.promoDescription}}. {{$productOrderCtrl.translations['antibody.pdp.commerceCard.promotion.learnmore']}}
产品信息
15516-1-AP
种属反应
已发表种属
宿主/亚型
分类
类型
抗原
偶联物
形式
浓度
规格
纯化类型
保存液
内含物
保存条件
运输条件
产品详细信息
Immunogen sequence: MGWSCLVTGA GGLLGQRIVR LLVEEKELKE IRALDKAFRP ELREEFSKLQ NRTKLTVLEG DILDEPFLKR ACQDVSVVIH TACIIDVFGV THRESIMNVN VKGTQLLLEA CVQASVPVFI YTSSIEVAGP NSYKEIIQNG HEEEPLENTW PTPYPYSKKL AEKAVLAANG WNLKNGDTLY TCALRPTYIY GEGGPFLSAS INEALNNNGI LSSVGKFSTV NPVYVGNVAW AHILALRALR DPKKAPSVRG QFYYISDDTP HQSYDNLNYI LSKEFGLRLD SRWSLP
靶标信息
3 beta-hydroxysteroid dehydrogenase (3beta-HSD), also known as HSD3B1 or HSDB3, is a bifunctional enzyme that plays a crucial role in the synthesis of all classes of hormonal steroids. Two human 3beta-HSD proteins, designated type I (3beta-HSD) and type II (3beta-HSD2), are expressed by different genes and function in different areas of the body. Localized to the membrane of the endoplasmic reticulum (ER) and expressed in skin and placenta, 3beta-HSD is the type I protein that catalyzes the oxidative conversion of delta5-ene-3-beta-hydroxy steroid, as well as the conversion of various ketosteroids. Defects in the gene encoding 3beta-HSD are associated with classic salt wasting, genital ambiguity, hypogonadism, insulin-resistant polycystic ovary syndrome (PCOS) and an increased susceptibility to prostate cancer. Additionally, congenital deficiency of 3beta-HSD activity results in a severe depletion of steroid formation which can be lethal in young children.
仅用于科研。不用于诊断过程。未经明确授权不得转售。
生物信息学
蛋白别名: 3 beta HSD II; 3 beta-HSD type II; 3 beta-hydroxysteroid dehydrogenase 2; 3 beta-hydroxysteroid dehydrogenase 6; 3 beta-hydroxysteroid dehydrogenase type II, delta 5-delta 4-isomerase type II, 3 beta-HSD type II; 3 beta-hydroxysteroid dehydrogenase/Delta 5-->4-isomerase type 2; 3 beta-hydroxysteroid dehydrogenase/Delta 5-->4-isomerase type 4; 3 beta-hydroxysteroid dehydrogenase/Delta 5-->4-isomerase type II; 3 beta-hydroxysteroid dehydrogenase/Delta 5-->4-isomerase type IV; 3-beta-HSD adrenal and gonadal type; 3-beta-HSD II; 3-beta-HSD IV; 3-beta-hydroxy-5-ene steroid dehydrogenase; 3-beta-hydroxy-Delta(5)-steroid dehydrogenase; 3beta-HSD; delta 5-delta 4-isomerase type II; HSD-3beta; Hydroxy-delta-5-steroid dehydrogenase 3 beta- and steroid delta-isomerase; hydroxysteroid dehydrogenase-2, delta<5>-3-beta; hydroxysteroid dehydrogenase-6 delta<5>-3-beta; progesterone reductase; short chain dehydrogenase/reductase family 11E, member 2; unnamed protein product
基因别名: HSD3B; Hsd3b1; HSD3B2; Hsd3b6; HSDB; HSDB3B; SDR11E2
UniProt ID: (Human) P26439, (Mouse) P26149, (Rat) Q62878
Entrez Gene ID: (Human) 3284, (Mouse) 15493, (Rat) 29632